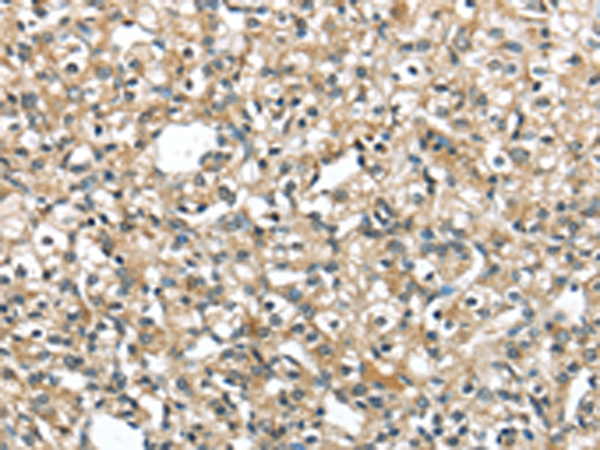

|
Background: |
Binds to the signal sequence of presecretory protein when they emerge from the ribosomes and transfers them to TRAM (translocating chain-associating membrane protein). |
|
Applications: |
ELISA, WB, IHC |
|
Name of antibody: |
SRP54 |
|
Immunogen: |
Fusion protein of human SRP54 |
|
Full name: |
signal recognition particle 54kDa |
|
SwissProt: |
P61011 |
|
ELISA Recommended dilution: |
1000-2000 |
|
IHC positive control: |
Human prostate cancer |
|
IHC Recommend dilution: |
25-100 |
|
WB Predicted band size: |
56 kDa |
|
WB Positive control: |
Human bladder carcinoma tissue |
|
WB Recommended dilution: |
200-1000 |

購物車
購物車 幫助
幫助
 021-54845833/15800441009
021-54845833/15800441009
